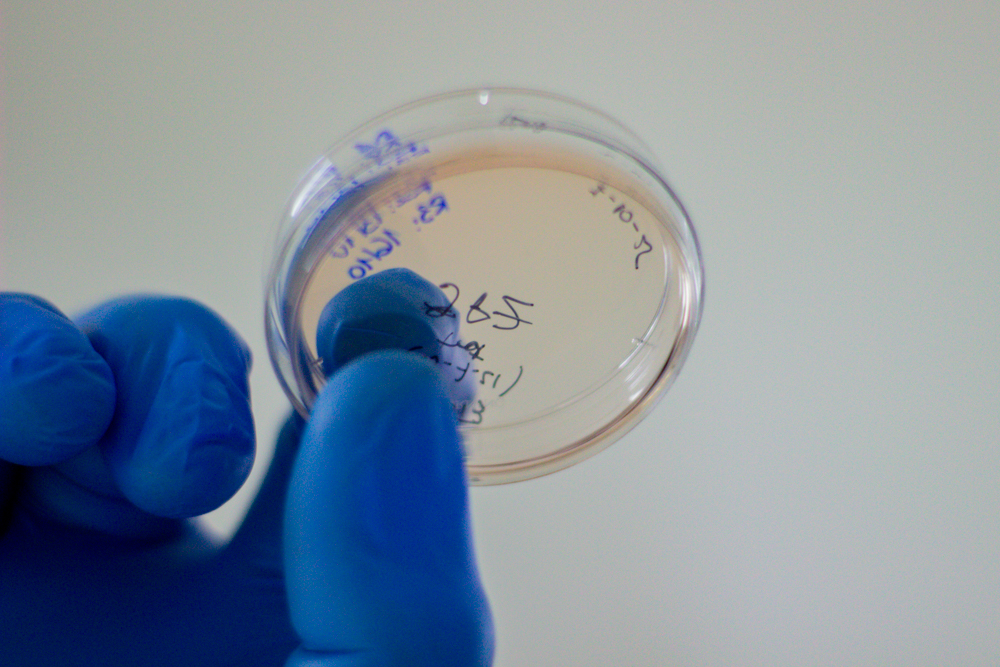

En octubre, las ciudades y las redes se pintan de rosa para impulsar el Mes de Sensibilización sobre el Cáncer de Mama. Desde hace años, el trabajo de la comunidad científica de la Facultad de Ciencias Químicas (UNC), va mucho más allá de este mes.
En laboratorios de la FCQ, diferentes líneas vienen avanzando en investigaciones orientadas a enfrentar esta problemática que, en Argentina, representa la principal causa de muerte por tumores en mujeres, siendo el tumor más frecuente en la población femenina.
Los desarrollos en ciencia básica de estos equipos tienen como eje a la inmunoterapia, el estudio de células poco conocidas, el análisis de biomarcadores y el comportamiento de vesículas extracelulares, con el fin de diseñar tratamientos más personalizados e innovadores. La mayoría comenzó a ejecutarse años atrás mediante el aporte de organismos oficiales y, en algunos casos, a través de becas y premios internacionales.
Uno de los trabajos pioneros es liderado por Germán Gil desde 2006. El proyecto se denomina “Rol del microambiente tumoral en cáncer de mama: implicancias biológicas y potenciales terapéuticos” y estudia cómo las células que rodean al tumor pueden influir en la progresión del cáncer y en la respuesta a tratamientos hormonales.
A través del Programa de Repatriación de Científicos Raíces, en 2010, Gil regresó al país para conformar un equipo y seguir investigando. “Primero, nos preguntamos sobre los receptores de estrógeno y la resistencia al tamoxifeno; luego, sobre el papel del sistema inmune y los macrófagos; y recientemente, sobre las vesículas extracelulares como mediadores de comunicación entre las células del tumor y su entorno”, recordó.
Otro grupo que aborda el microambiente tumoral es el dirigido por Carolina Montes. “Inicié con este proyecto en 2009, al regresar de mi estadía posdoctoral en Estados Unidos”, explicó la directora del proyecto “Estudio de las poblaciones de linfocitos T y B presentes en el microambiente tumoral: perspectivas para la inmunoterapia”.
Junto a su equipo, la docente e investigadora estudia las células y las moléculas del microambiente tumoral mediante el uso de modelos experimentales como así también de muestras de tumores de pacientes con cáncer de mama. Su objetivo es hallar biomarcadores para postular nuevos métodos de inmunoterapia. “Buscamos entender cómo las células del sistema inmune actúan en las distintas etapas del desarrollo tumoral para poder eliminar el tumor”, indicó Montes.
Asimismo, desde 2021, Nicolás Núñez lidera el proyecto “Firmas inmunológicas predictivas de respuesta a inmunoterapia en cáncer de mama HER2 negativo”, con la finalidad de descubrir marcadores que permitan anticipar si una paciente va a responder o no a la terapia.
“Estudiamos a la inmunoterapia que, a diferencia de la quimioterapia, no ataca al tumor, sino que estimula las defensas naturales del cuerpo, reforzando a los “soldados” del sistema inmune para que reconozcan y eliminen las células cancerosas”, graficó Núñez.
En 2023, este proyecto recibió un subsidio para continuar con sus estudios y una beca de intercambio con la Universidad de Zúrich (Suiza), donde se llevan adelante parte de los análisis de las muestras mediante tecnología de última generación.

En busca de tratamientos más eficaces
Este año, el equipo de Germán Gil publicó un trabajo en la revista Frontiers, que demuestra cómo pequeñas vesículas (EVS) liberadas por los macrófagos modifican el comportamiento de las células tumorales, volviéndolas resistentes al tratamiento.
“Estas vesículas inducen un cambio en la identidad celular conocido como transición epitelio-mesenquimal (EMT), que vuelve a las células más móviles y agresivas. Además, promueven la aparición de un subgrupo con características de células madre tumorales, más resistentes a los tratamientos. En el laboratorio, también observamos que las vesículas del tumor pueden reprogramar a los macrófagos y favorecer un entorno inmunosupresor, lo que ayuda al tumor a evadir la defensa del organismo”, comentó Gil.

Junto a un equipo interdisciplinario, el científico trabaja en estrategias innovadoras para revertir la resistencia de las células con cáncer a los tratamientos, combinando nanotecnología y farmacología. En colaboración con otros grupos, también desarrolla nanomateriales mesoporosos para transportar tamoxifeno (medicamento antiestrógeno para tratar cáncer de mama) y combinarlo con terapia fotodinámica, una técnica que usa la luz para activar compuestos dentro del tumor.
El objetivo es diseñar tratamientos más eficaces y personalizados para pacientes con cáncer de mama ER+, colaborando así con su supervivencia. Los próximos desafíos implican identificar las moléculas clave dentro de las vesículas que causan estos efectos —proteínas, microARNs— y validar su función en modelos animales para luego pasar a la fase de aplicaciones clínicas.
“Buscamos establecer metodologías robustas para aislar y analizar este tipo de vesículas en muestras biológicas humanas, de modo tal que luego podamos realizar determinaciones en pacientes con cáncer de mama y correlacionar moléculas diana con la respuesta al tratamiento hormonal y la progresión de la enfermedad”, dijo Gil.

Moléculas y mecanismos inmunológicos que trascienden
En su laboratorio, junto a becarias, estudiantes y colegas, Carolina Montes logró importantes avances en el conocimiento de células del sistema inmune que tienen un papel protagónico en la respuesta antitumoral, como los linfocitos T CD8. Además, en los últimos años, su equipo se abocó al estudio de los linfocitos B, una población celular cuya participación en el microambiente tumoral es controvertida.
Junto a investigadores franceses del Instituto Curie, además, este equipo estudió las células que infiltran los tumores y ganglios linfáticos que drenan los tumores de pacientes con cáncer de mama, para evaluar la funcionalidad de las células T CD8 en ambos tejidos.

“Este año, publicamos un trabajo científico en el que hicimos un gran aporte al demostrar que hay células que reconocen antígenos tumorales que están presentes no sólo en el tumor, sino también en los ganglios drenantes de las pacientes. Este tipo de hallazgos aportan herramientas valiosas a la hora del diseño de inmunoterapias”, sostuvo Montes.
Para la científica, estos trabajos de ciencia básica constituyen grandes aportes a la lucha contra el cáncer de mama a nivel mundial. “Estudiamos moléculas y mecanismos inmunológicos básicos, que resultan fundamentales para aportar al conocimiento que hacemos los científicos en todo el mundo. Gracias a esos pequeños aportes diarios, hoy la inmunoterapia es una herramienta valiosísima en el tratamiento del cáncer de mama y de cánceres de distintos orígenes histológicos”, dijo.
Ahora, el grupo está abocado a terminar estudios sobre diferentes posibilidades terapéuticas mediante la combinación de distintas estrategias utilizando modelos experimentales, una de las tendencias científicas en este campo.

Hacia una medicina personalizada
El estudio de señales en la sangre que indican si la inmunoterapia será efectiva o no en personas con cáncer de mama resulta clave para que las y los médicos puedan anticiparse y elegir el tratamiento más adecuado en cada caso. Esto, a la vez, permite ahorrar tiempo, evita terapias inadecuadas y reduce efectos secundarios.
Por eso, el trabajo que realiza la becaria doctoral Sabrina Dhooge tendrá impacto directo en la forma de tratar este tipo de cánceres en el futuro. Según el bioquímico, “este proyecto busca que cada paciente reciba un tratamiento adaptado a su sistema inmune, avanzando hacia una medicina verdaderamente personalizada. Además, podría permitir controlar la evolución del cáncer con un simple análisis de sangre, sin necesidad de biopsias u otros procedimientos invasivos”.
En los laboratorios del Centro de Investigaciones en Bioquímica Clínica e Inmunología (CIBICI, UNC-CONICET), este equipo identificó que algunas células de defensa del cuerpo se comportan de manera diferente en pacientes que mejoran con inmunoterapia frente a aquellas en las que no hay buenos resultados. “Ciertos glóbulos blancos mostraron señales de “cansancio” o de baja actividad en pacientes que no responden bien a este tipo de tratamientos”, ejemplificó el científico.

A través del análisis de los genes, el grupo continúa observando de cerca a cada célula mediante tecnologías que permiten ver qué hacen y cómo se comunican entre sí dentro del sistema inmune. Asimismo, analiza marcadores presentes en el suero mediante la detección de sustancias que circulan en la sangre, las cuales pueden resultar señales tempranas de respuesta o de resistencia al tratamiento.
Estos estudios se realizan junto a científicos de la Universidad de Zúrich y del Centro Nacional Oncológico (CNO) de Madrid. En una segunda etapa, los resultados serán validados con pacientes de centros de salud locales, como el Hospital Privado de Córdoba, donde algunos integrantes de su equipo médico participan del proyecto.

La investigación como aliada de la prevención
Las y los científicos de la FCQ coinciden en que la prevención sigue siendo la principal herramienta en la lucha contra el cáncer de mama: las campañas, los controles periódicos, las mamografías y la atención médica inmediata resultan claves.
La mayoría de los estudios que se desarrollan en los laboratorios de la Facultad tiene como eje al tratamiento, una vez detectado el tumor. Sin embargo, muchos de los avances de estas líneas también pueden establecer puentes con la detección temprana, identificando aportes muy significativos para la salud de las personas.

“Nuestro trabajo está enfocado en mejorar los tratamientos, pero también ayuda a entender mejor cómo el cuerpo reconoce y combate al cáncer, lo que en el futuro podría servir para diseñar estrategias preventivas o, incluso, vacunas terapéuticas”, anticipó Nicolás Núñez.
En el caso del estudio de las vesículas extracelulares, según Germán Gil, al circular en sangre y reflejar la información molecular del tumor, éstas podrían “servir como biomarcadores en biopsias líquidas, es decir, en análisis de sangre que detecten cambios asociados a la progresión o a la resistencia del tratamiento”.
Equipos
“Rol del microambiente tumoral en cáncer de mama: implicancias biológicas y potenciales terapéuticos”
Director: Germán Gil.
Equipo: Cecilia Rodríguez Balli, Marcela Diez, Juan Pablo Zanin y Cecilia Sambrook.
Colaboradores: César Prucca (terapia fotodinámica), Gabriel Ferrero y Paola Carraro. (nanomateriales mesoporosos).
“Estudio de las poblaciones de linfocitos T y B presentes en el microambiente tumoral: perspectivas para la inmunoterapia”.
Directora: Carolina Montes.
Equipo: Carolina Abrate, Valentina Brunotto y Lucía Amarante.
Colaboradoras de la FCQ: Adriana Gruppi y Eva Acosta Rodríguez.
Colaboradores externos: Eliane Piaggio (Instituto Curie, Francia), Simon Robson (Harvard University, Estados Unidos), Fernando Canale (Universidad de Zúrich) y Andrés del Castillo (Polo Hospitalario, provincia de Córdoba)
“Firmas inmunológicas predictivas de respuesta a inmunoterapia en cáncer de mama HER2 negativo”
Directores: Nicolás Núñez y Mariana Maccioni.
Equipo: Sabrina Dhooge, Lucía Boffelli, Pilar Biasi, Ana Flores Guirado, Jeremías Dutto y Jeremías Bustos.
Colaboradores externos: Universidad de Zúrich, Centro Nacional Oncológico (CNO) de Madrid y Hospital Privado Córdoba.


